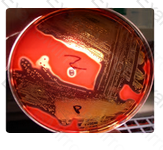
Question # 16

Pre-Summer Special Limited Time 70% Discount Offer - Ends in 0d 00h 00m 00s - Coupon code = getmirror
Pass the ASCP MLT(ASCP) ASCP-MLT Questions and answers with ExamsMirror
Exam ASCP-MLT Premium Access
View all detail and faqs for the ASCP-MLT exam
891 Students Passed
87% Average Score
92% Same Questions
Streptococcus pyogenes is the correct answer. Streptococcus pneumoniae is alpha-hemolytic which demonstrate a green area of partial hemolysis around the colonies. Staphylococcus aureus will produce complete hemolysis but is catalase positive. Streptococcus agalactiae is beta-hemolytic but only produces a partial clearing of the red blood cells in sheep blood agar.
Complete hemolysis of sheep blood agar as demonstrated by the image below would be seen in which of the following catalase-negative isolates?
The membranes of ion selective electrodes will determine which analyte is measured by the electrode.
Chemistry
The selectivity of an ion-selective electrode is determined by the:
In which disorder do neonates demonstrate the presence of Bart's hemoglobin that changes to beta chain tetramers in adults?
Fusarium species is the most likely associated with mycotic keratitis.
Trichophyton rubrum is a dermatophyte that commonly causes an itching, scaling skin infection of the feet, known as tinea pedis. Scedosporium apiospermum is commonly associated with sinusitis. Aspergillus niger typically causes otitis externa and can also be associated with sinusitis.
Which of the following species or organisms is the most likely to be the cause of mycotic keratitis (fungal eye infection)?
The risk of HbS polymerization is enhanced by a low (acid) pH, a state of dehydration, and increased levels of 2,3-DPG. Increased temperature (above 37°C) also adds to the risk.
Hematology
Which group of conditions INCREASES the risk of HbS polymerization?
Match the type of media with the phrase that best describes that media:
1. Differential
2. Selective
3. Enrichment
Report the isolate as coagulase negative Staphylococcus is the correct answer because this is an isolate from a urine specimen with a coagulase negative Staphylococcus susceptible to novobiocin. Staphylococcus saprophyticus is resistant to novobiocin. Further testing is required to speciate coagulase negative Staphylococci but only if the specimen is from a sterile body site, not urine.
Gram positive cocci isolated from a catheterized urine culture on a 76-year-old male gave the following reactions:
Blood agar- creamy, white, opaque colonies
Catalase- positive
Slide coagulase- negative
Tube coagulase- negative
Novobiocin- susceptible
The next action the MLS should take is:
The indole (modified Kovacs' reagent) is used to assess the ability of certain bacteria to produce indole by the deamination of tryptophan. Indole reacts with aldehyde in the Kovac's reagent to produce a red color. An alcoholic layer holds the red color as a ring at the top of the tube used for the idole test.
If a bacteria produces the enzyme tryptophanase to break down the amino acid tryptophan, which of the following tests will be positive with Kovac's reagent?
Interferon gamma serves various purposes in immunologic response, including the promotion of natural killer cell activity as well as decreased viral replication by using enzymes to decrease protein replication, both viral or host, inside of the cell.
The lymphokine most important for increased natural killer cell activity and decreased viral replication in cells is:
Platelets do not circulate in inactivated, spiny forms. The spiny, sticky form of the platelet is initiated once the platelets become activated in response to blood vessel damage.
Which of the following is not true in terms of platelet characteristics?
One of the key characteristics to the identification of Nocardia asteroides is its inability to hydrolyze casein, tyrosine or xanthine, as shown in this photograph. Nitrates are reduced to nitrites. Both Nocardia brasiliensis and Actinomadura madurae hydrolyze both casein and tyrosine; Streptomyces griseus hydrolyzes all three of the substrates.
Illustrated in this photograph is an agar quadrant plate containing casein (A), tyrosine (B), nitrate (C) and xanthine (D). None of the substrates have been hydrolyzed and nitrate has been reduced. The most likely identification is:

Blood bank
Which of the following is the most common subgroup of A?
As a general rule, CSF glucose is about two thirds of the serum glucose measured in a normal adult.
Chemistry
Which of the following would be considered a normal cerebrospinal fluid glucose if the serum glucose is 70 mg/dl?
Which of the following is most likely to interact with arterial walls, leading to deposition of cholesterol, and initiating or worsening atherosclerosis?
n reporting out Gram stains, one should not go beyond what objective observation will allow. In this case, bacterial cells are observed, which are spherical and gram-positive. Their arrangement in tetrads and clusters might be helpful to the physician, suggesting staphylococci. However, one should stop short of naming staphylococci in an official report, as the large gram-positive cocci in tetrads is also suggestive of Micrococcus species, for which human infections have not been reported.
A Gram stain of the serous exudate is shown in the image. The appropriate report would read:

TOP CODES
Top selling exam codes in the certification world, popular, in demand and updated to help you pass on the first try.